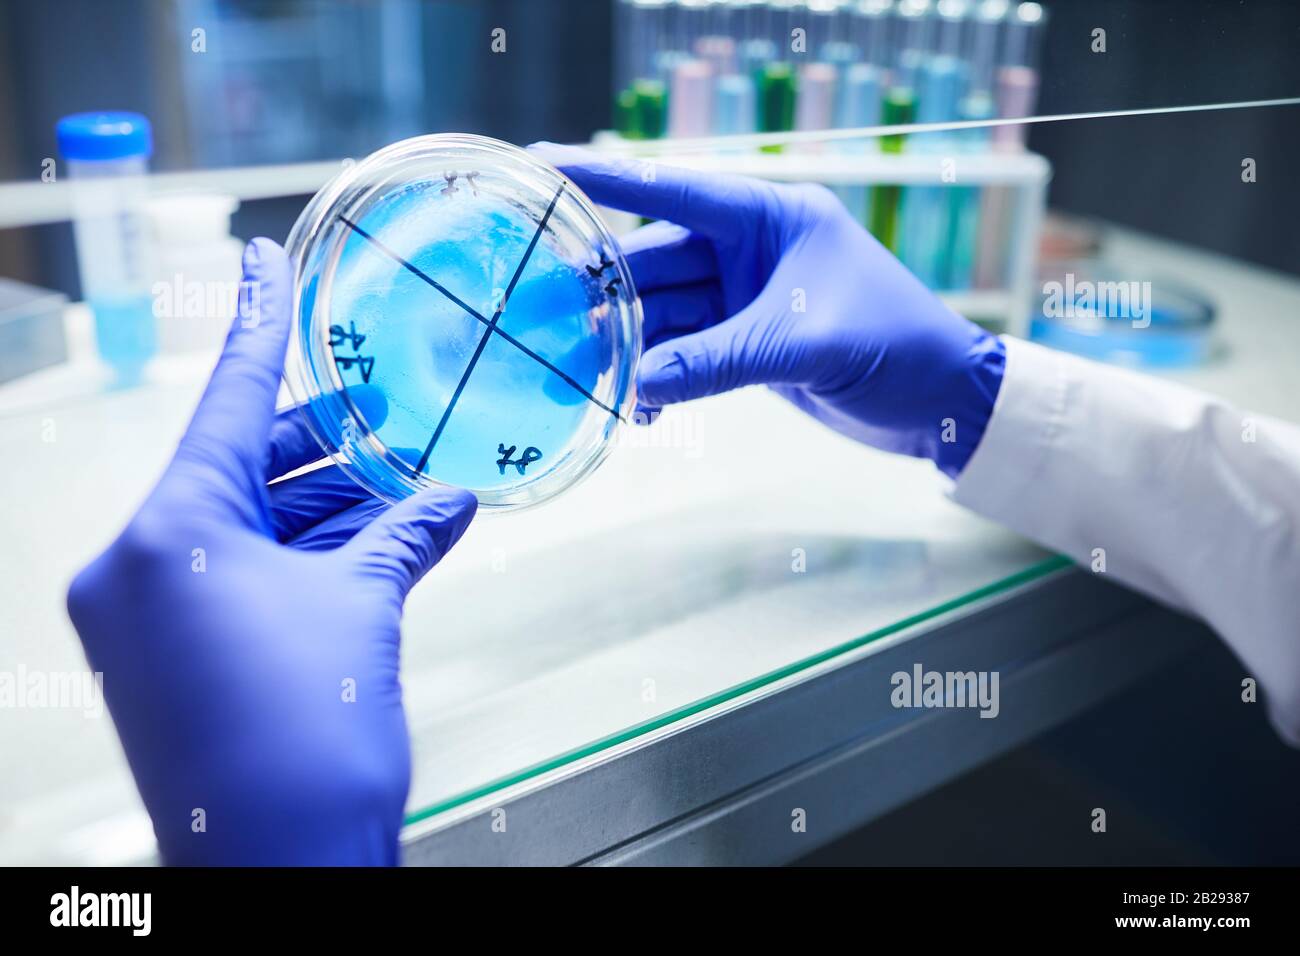
Gros plan de scientifique avec des mains gantées tenant la boîte de Petri tout en travaillant sur la bio-recherche en laboratoire, espace de copie Banque D'Images

équipement de labo Photos Stock & Des Images
(1,436)équipement de labo Photos Stock & Des Images

RF2B2954N–Fermeture extrême de l'aiguille de seringue prenant des médicaments à partir d'un flacon en verre, antécédents médicaux avec espace de copie

RF2B29536–Gros plan des flacons en verre en ligne sur bleu dans un laboratoire médical, espace de copie

RF2M17WJD–Portrait d'homme noir regardant au microscope et travaillant à la recherche médicale en laboratoire

RF2M1KDYA–Portrait d'homme noir regardant au microscope et travaillant à la recherche médicale en laboratoire

RF2B294W6–Vue de dessus image de fond de seringue et ampoules en verre dispersées sur une table blanche en laboratoire médical, espace de copie

RF2B296FH–Taille vers le haut portrait d'un scientifique masculin portant un équipement de biodanger examinant les tubes à essai tout en travaillant sur la recherche en bio-laboratoire, espace de copie

RF2B29468–Portrait de la femme scientifique regardant au microscope tout en travaillant sur la recherche en laboratoire médical, espace de copie

RF2B294RJ–Vue du dessus image d'arrière-plan des ampoules en verre dispersées sur une table blanche en laboratoire, espace de copie

RF2B294PC–Vue ci-dessus arrière-plan des tubes à essai avec liquide coloré sur table blanche en laboratoire médical, espace de copie

RF2B29577–Proximité extrême du chauffage des échantillons de sang par incendie de gaz en laboratoire médical, contexte avec espace de copie

RF2B294XG–Vue du dessus image d'arrière-plan des flacons en verre en ligne sur la table blanche dans le laboratoire médical, espace de copie

RF2AMJ4FA–Portrait de l'optométriste masculin souriant à l'appareil photo tout en posant sur le lieu de travail par équipement optique, espace de copie

RF2AMJ4TA–Tête et épaules portrait de l'optométriste masculin souriant à l'appareil photo tout en posant sur le lieu de travail par équipement optique, espace de copie

RF2M17X0F–Portrait vertical d'un scientifique mâle utilisant un microscope dans un laboratoire médical

RF2B296DJ–Taille vers le haut portrait d'un scientifique masculin portant des équipements de biodanger tenant des tubes à essai tout en travaillant sur la recherche en bio-laboratoire, espace de copie

RF2AMJ4H5–Portrait à faible angle de l'optométriste mâle à l'aide d'une machine réfractomètre tout en testant la vision d'un patient non reconnaissable

RF2B293CY–Gros plan de scientifique avec des mains gantées tenant la seringue avec du sang tout en travaillant sur la bio-recherche en laboratoire, espace de copie

RF2M182W4–Gros plan vertical d'un technicien de laboratoire afro-américain qui prélève des échantillons liquides avec une pipette

RF2AYTM8B–Image d'arrière-plan des semences dispersées dans un plateau métallique dans une pépinière agricole ou un laboratoire biologique, espace de copie

RF2M184C8–Vue latérale d'un scientifique noir utilisant un microscope dans un laboratoire médical, espace de copie

RF2M1KGKF–Vue latérale d'un scientifique noir utilisant un microscope dans un laboratoire médical, espace de copie

RF2M17W58–Vue en grand angle chez un scientifique noir qui regarde au microscope tout en travaillant dans un laboratoire médical

RF2M17W6F–Portrait d'un homme afro-américain utilisant un microscope tout en faisant des recherches en laboratoire médical

RF2M1KDGR–Portrait d'un homme afro-américain utilisant un microscope tout en faisant des recherches en laboratoire médical

RF2M17W5R–Portrait d'un homme afro-américain utilisant un microscope tout en faisant des recherches en laboratoire médical

RF2M17WT5–Portrait vertical d'un scientifique afro-américain effectuant des analyses de sang en laboratoire médical à la clinique

RF2M1KE5J–Portrait vertical d'un scientifique afro-américain effectuant des analyses de sang en laboratoire médical à la clinique

RF2M17WXR–Portrait vertical d'un scientifique afro-américain effectuant des analyses de sang en laboratoire médical à la clinique

RF2AMKKRW–Portrait de vue latérale de la jeune ophtalmologiste féminine utilisant une machine réfractomètre pendant le test de vision dans une clinique moderne

RF2AMJ4KE–Portrait de l'optométriste masculin à l'aide d'une machine réfractomètre tout en testant la vision d'un patient non reconnaissable

RF2AMJ4T8–Gros plan portrait de l'optométriste mâle utilisant une machine réfractomètre tout en testant la vision d'un patient non reconnaissable

RF2B294HR–Image d'arrière-plan des tubes à essai avec liquide coloré sur la table dans un laboratoire à lumière bleue, espace de copie

RF2B2961M–Portrait vertical du scientifique en costume de protection complet tenant des tubes à essai tout en travaillant sur la recherche en laboratoire

RF2B293EF–Portrait de la scientifique féminine qui examine l'échantillon sanguin tout en travaillant sur la recherche biologique en laboratoire, copier l'espace

RF2B2964B–Vue latérale portrait de deux scientifiques portant un équipement de risque biologique travaillant sur la recherche en laboratoire médical, espace de copie

RF2B294FY–Portrait de la scientifique féminine effectuant un test sanguin tout en travaillant sur la recherche en laboratoire médical, espace de copie

RF2M1KG8H–Gros plan d'un scientifique noir prenant des échantillons liquides avec une pipette en laboratoire, dans l'espace de copie

RF2B29306–Vue latérale portrait d'un scientifique féminin portant un masque et un équipement de protection qui dépose des échantillons de sang dans des tubes à essai tout en travaillant à la recherche en laboratoire,

RF2B296PG–Portrait de deux scientifiques portant des équipements de biodanger tout en travaillant sur la recherche en bio laboratoire

RF2B2967J–Portrait de deux scientifiques portant des équipements de risque biologique travaillant sur la recherche en laboratoire médical, espace de copie

RF2B292PX–Vue latérale portrait d'un scientifique féminin portant un masque facial et un équipement de protection travaillant sur la recherche en laboratoire, espace de copie

RF2B2948E–Vue de dessus contexte du scientifique tenant la boîte de Petri à côté du microscope tout en travaillant sur la bio-recherche en laboratoire, espace de copie

RF2B2935K–Gros plan d'un scientifique non reconnaissable tenant un plat de Petri tout en travaillant sur la recherche biologique en laboratoire, espace de copie

RF2B29455–Gros plan portrait de la scientifique féminine regardant au microscope tout en travaillant sur la recherche en laboratoire médical, espace de copie

RF2B293A0–Gros plan sur les femmes scientifiques avec des mains gantées tenant la seringue avec du sang tout en travaillant sur la bio-recherche en laboratoire, espace de copie

RF2B293X5–Portrait de la scientifique féminine regardant au microscope tout en travaillant sur la recherche en laboratoire médical, espace de copie

RF2B2970Y–Gros plan de deux scientifiques examinant des échantillons de sang sur un panneau lumineux en laboratoire médical, espace de copie

RF2B292NJ–Image d'arrière-plan gros plan des tubes à essai avec un liquide coloré sur la table en laboratoire, espace de copie

RF2B292W0–Portrait d'une femme scientifique portant un masque et un équipement de protection qui dépose des échantillons de sang dans des tubes à essai tout en travaillant sur la recherche en laboratoire, dans l'espace de copie

RF2B2931K–Gros plan sur un scientifique non reconnaissable qui tient un tube à essai avec un échantillon de sang tout en travaillant sur la recherche en laboratoire, espace de copie

RF2B292XM–Gros plan sur les femmes scientifiques portant un masque et des équipements de protection qui redescendent des échantillons de sang dans des tubes à essai tout en travaillant sur la recherche en laboratoire, dans l'espace de copie
RF2B29387–Gros plan de scientifique avec des mains gantées tenant la boîte de Petri tout en travaillant sur la bio-recherche en laboratoire, espace de copie

RF2B293P2–Arrière-plan extrêmement rapproché des tubes à essai avec un liquide coloré sur la table dans le laboratoire de recherche, espace de copie

RF2B29335–Gros plan d'un scientifique non reconnaissable tenant un tube à essai avec un échantillon sanguin tout en travaillant sur la recherche en laboratoire, espace de copie

RF2B296RK–Portrait de deux scientifiques portant des équipements de biodanger tout en travaillant sur la recherche en laboratoire biologique, espace de copie

RF2B295A2–Au-dessus de la vue contexte du scientifique examinant l'échantillon de sang en laboratoire médical, copier l'espace

RF2B296AT–Portrait de deux scientifiques portant un équipement de protection complet travaillant sur la recherche en laboratoire médical, espace de copie

RF2B292T2–Gros plan sur l'échantillonnage du sang des femmes scientifiques dans les tubes à essai tout en travaillant sur la recherche en laboratoire, espace de copie

RF2B295C3–Portrait d'un scientifique examinant l'échantillon sanguin en laboratoire médical pendant la recherche, copier l'espace

RF2B292YN–Gros plan sur les scientifiques non reconnaissables qui transpirent des échantillons de sang dans des tubes à essai tout en travaillant sur la recherche en laboratoire, dans l'espace de copie

RF2B29510–Vue de dessus arrière-plan des mains gantées tenant des flacons en verre en rangée sur la table blanche dans le laboratoire médical, espace de copie

RF2B29612–Au-dessus de la vue arrière-plan de la seringue et du sang qui déborde autour de l'échantillon du tube à essai en laboratoire médical, espace de copie

RF2AMKE4P–Prise de vue de jeune optométriste mettant des lunettes sur un patient non reconnaissable pendant le test de vision dans une clinique moderne, espace de copie

RF2AMKE93–Prise de vue de l'optométriste souriant mettant des lunettes sur un patient non reconnaissable pendant le test de vision dans une clinique moderne, espace de copie

RF2DE7B0B–Image d'arrière-plan du microscope électronique et des jeunes plants sur la table d'équipement en laboratoire de biotechnologie, espace de copie

RF2B29407–Portrait de la scientifique féminine regardant au microscope tout en travaillant sur la recherche en laboratoire médical, espace de copie

RF2B294ET–Vue à faible angle chez les femmes scientifiques effectuant un test sanguin tout en travaillant avec un microscope en laboratoire médical, espace de copie

RF2B29474–Portrait vertical de la scientifique féminine portant un équipement de protection complet en laboratoire sur la recherche biologique

RF2B294DE–Gros plan sur les femmes scientifiques utilisant un microscope tout en travaillant sur la recherche en laboratoire médical

RF2B294B9–Portrait de la scientifique féminine regardant au microscope tout en travaillant sur la recherche en laboratoire médical

RF2B2949R–Portrait de la scientifique féminine regardant au microscope tout en travaillant sur la recherche sur les risques biologiques en laboratoire, espace de copie

RF2B29342–Portrait d'une scientifique féminine tenant un tube à essai avec un échantillon sanguin tout en travaillant sur la recherche en laboratoire, espace de copie



























